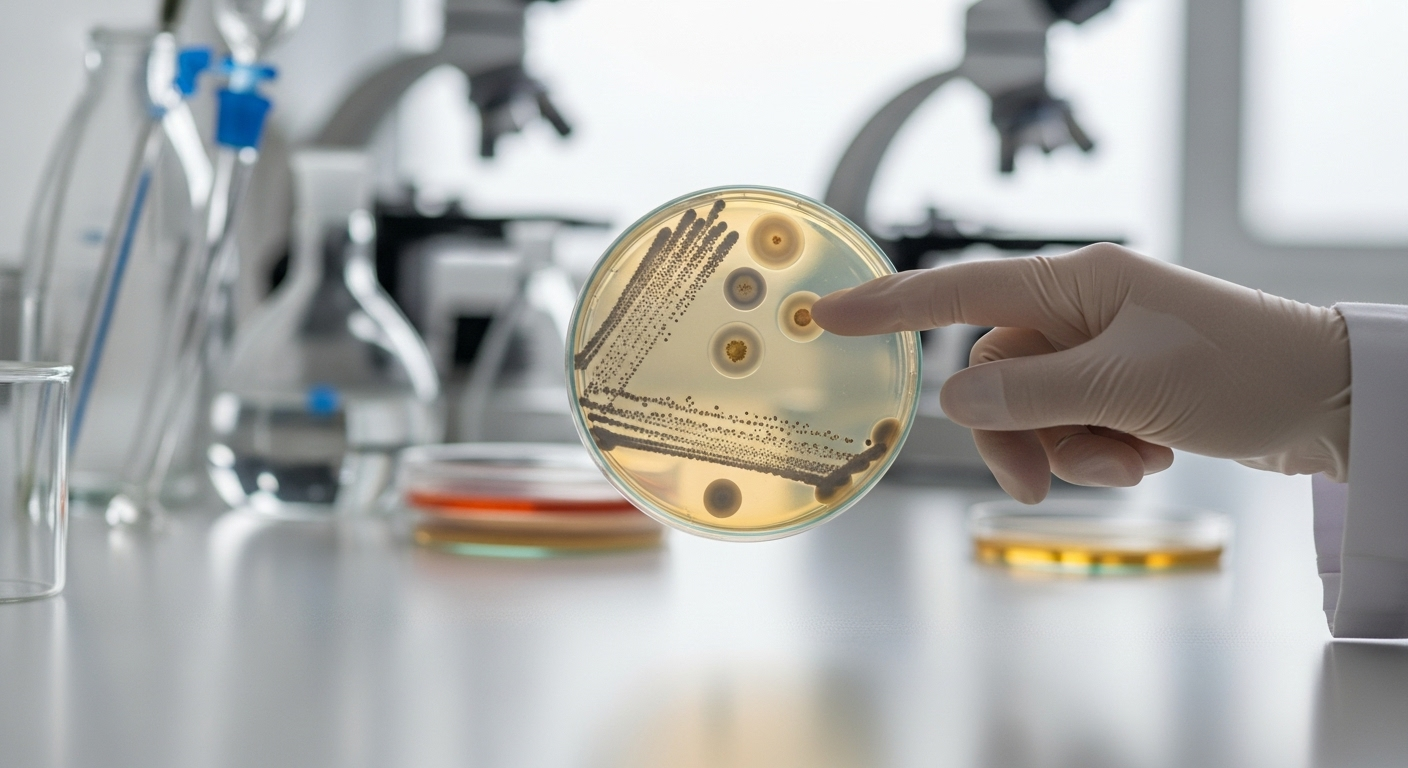
La mélioïdose, une maladie rare et redoutable

Un mystère médical : Leurs infections seraient liées à des décès survenus dans les années 1980.
Auteur: Mathieu Gagnon
Imaginez un peu. Deux hommes tombent gravement malades l’année dernière, presque en même temps, dans le même comté de Géorgie. Au début, on pourrait penser à une simple coïncidence. Mais ce qui rend cette histoire vraiment déroutante, c’est que leur maladie est directement liée à deux décès survenus dans les années 80. Oui, vous avez bien lu. Une bactérie rare, normalement trouvée à l’autre bout du monde, semble avoir tissé un lien invisible à travers quarante années.
Comment est-ce possible ? C’est toute la question qui a mobilisé les chercheurs. Ils ont découvert une histoire fascinante, presque un thriller médical, qui suggère qu’un danger invisible dort sous nos pieds depuis bien plus longtemps qu’on ne l’imaginait.
L'ouragan Helene, le grand réveil d'une bactérie endormie

Tout a commencé en septembre 2024. Deux hommes, l’un dans la cinquantaine et l’autre dans la soixantaine, sont tombés malades à un jour d’intervalle. Le point commun ? Ils ont tous les deux travaillé dehors pendant le passage catastrophique de l’ouragan Helene. Ils étaient sur le même chantier, exposés à la boue, à la poussière, au vent et à des pluies torrentielles. L’un inspectait des véhicules, l’autre conduisait des engins de chantier. Quelques jours plus tard, le verdict tombe : ils sont infectés par une bactérie qu’on ne s’attendait pas du tout à trouver là.
Les scientifiques pensent que c’est l’ouragan, avec toute sa fureur, qui a remué la terre et permis à cette bactérie cachée de se libérer et d’infecter ces deux travailleurs. Un peu comme si la tempête avait réveillé un vieux monstre endormi.
La mélioïdose, une maladie rare et redoutable
La maladie en question s’appelle la mélioïdose. Elle est causée par une bactérie au nom compliqué, Burkholderia pseudomallei, qui vit habituellement dans le sol des régions tropicales comme l’Asie du Sud-Est. On peut l’attraper en la respirant ou si elle entre en contact avec une coupure sur la peau. Ce n’est pas une petite infection.
Elle est très difficile à diagnostiquer et encore plus à traiter, car elle résiste naturellement à beaucoup d’antibiotiques. Si elle n’est pas traitée, le taux de mortalité peut grimper jusqu’à 90%. C’est énorme. Heureusement, avec des soins rapides et adaptés, ce chiffre tombe à moins de 40%. Mais ça reste une maladie très sérieuse qui peut se propager dans tout le corps, jusqu’au cerveau.
Un combat pour la vie et une rechute inquiétante

Heureusement pour les deux hommes de 2024, les médecins ont rapidement compris la gravité de la situation. Ils ont été hospitalisés pour un état de septicémie – c’est quand l’infection se généralise dans le sang – et ont reçu de lourds traitements antibiotiques. Ils ont tous les deux réussi à s’en sortir.
Cependant, l’histoire ne s’arrête pas là. Le deuxième patient, celui dans la soixantaine, a fait une rechute en novembre. Il a dû être de nouveau hospitalisé. Ça montre bien à quel point cette bactérie est tenace. Finalement, il s’en est sorti une seconde fois, mais quelle épreuve…
La surprise des analyses : un lien avec les années 80

Ce qui a vraiment tout changé, c’est quand les chercheurs ont analysé l’ADN de la bactérie. C’est un peu comme faire un test de paternité pour un microbe. Et là, surprise totale ! La bactérie qui a infecté les deux hommes en 2024 était quasiment identique à celle qui avait tué deux autres hommes dans le même comté, mais en 1983 et 1989.
Personne ne s’y attendait. D’habitude, on trouve une douzaine de cas par an aux États-Unis, mais presque toujours chez des gens qui ont voyagé. Là, ce n’était pas le cas. Cette découverte a ouvert une porte sur le passé et a complètement changé la façon de voir les choses.
Les fantômes du passé : les victimes de 1983 et 1989

En se penchant sur les anciens dossiers, les enquêteurs ont retracé les histoires tragiques des deux premières victimes. L’homme décédé en 1989 était un vétéran du Vietnam. La bactérie étant présente là-bas, on aurait pu penser qu’il l’avait ramenée. Mais son infection est survenue 20 ans après son retour, ce qui est très rare. Fait troublant : un mois avant sa mort, l’ouragan Hugo, une tempête de catégorie 4, avait frappé la Géorgie.
Le cas de 1983 est encore plus mystérieux. Cet homme, également décédé, n’avait fait aucun voyage qui pourrait expliquer l’infection. Et pas d’ouragan cette année-là. Son seul lien ? Il travaillait sur une base militaire située à moins de deux kilomètres du chantier où les deux hommes de 2024 sont tombés malades.
Alors, la bactérie vit-elle en permanence en Géorgie ?

Toutes ces coïncidences sont trop grosses pour être ignorées. Les chercheurs pensent maintenant que la bactérie est probablement « endémique » dans cette région de la Géorgie. Ça veut dire qu’elle vit là, dans le sol, depuis des décennies. L’idée a été renforcée par une découverte similaire dans le Mississippi en 2022.
Une des théories est que la bactérie aurait pu être introduite dans l’environnement par le retour de personnel ou de matériel militaire de la guerre du Vietnam. La proximité de la base militaire avec les lieux d’infection est un indice assez fort. Mais pour en être certain, il faudrait trouver la bactérie directement dans des échantillons de terre, ce qui n’a pas encore été fait.
Le danger peut venir d'ailleurs, et c'est terrifiant

Et comme si l’histoire n’était pas assez inquiétante, il faut savoir que cette bactérie peut surgir là où on ne l’attend pas du tout. En 2021, une autre affaire avait secoué l’Amérique. Quatre personnes, dans quatre États différents, avaient été infectées.
Après enquête, la source a été identifiée : un spray d’ambiance pour aromathérapie vendu chez Walmart, qui contenait des pierres précieuses contaminées. C’est fou, non ? Sur les quatre cas, deux personnes sont décédées, dont un petit garçon de 5 ans en Géorgie. Une fillette de 4 ans a survécu mais avec des lésions cérébrales permanentes. Une histoire terrible qui nous rappelle que la vigilance est de mise, même avec des produits qui semblent inoffensifs.
Conclusion : un avertissement venu de la terre

Alors, que retenir de tout ça ? D’abord, que la nature a encore bien des secrets. Cette histoire nous montre qu’un danger peut rester silencieux, caché sous nos pieds pendant des décennies, avant d’être réveillé par un événement comme un ouragan.
Ça ne veut pas dire qu’il faut avoir peur de sortir dans son jardin. Mais ça nous rappelle d’être prudents, surtout après de fortes pluies ou des tempêtes, et de bien nettoyer les coupures si on a été en contact avec de la terre ou de la boue. On se croit en sécurité, et puis on découvre qu’un ennemi invisible dormait peut-être là depuis tout ce temps. Ça fait réfléchir, n’est-ce pas ?
Selon la source : arstechnica.com










